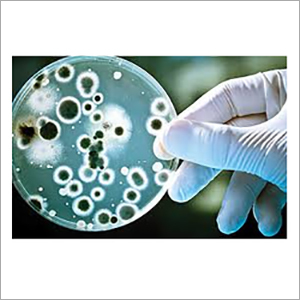
Slimicides Compound

Phenoxyethanol (Low Phenol)
Price:
Get Latest Price
In Stock
Product Specifications
| Purity | 99.5% |
| Packaging | Plastic bottles |
| Appearance | Colorless liquid |
| Solubility | Miscible with water |
| Density | 1.10-1.11 g/ml |
| Storage | Cool, dry place |
| CAS Number | 122-99-6 |
| Features | High purity, Long shelf life, Accurate composition, Various packaging, Wide applications, Cost effective, International standards |
Company Details
Business Type
Exporter, Manufacturer, Supplier
Employee Count
1500
Establishment
1987
Working Days
Monday To Sunday
Related Products
More Products From This Seller
Seller Details
Bicholim, Goa
International Marketing Manager
Mr. Jayesh Shirodker
Address
Plot No. 109-111, Bicholim Industrial Estate, Bicholim, Goa, 403529, India
phenoxyethanol in Bicholim
Report incorrect details